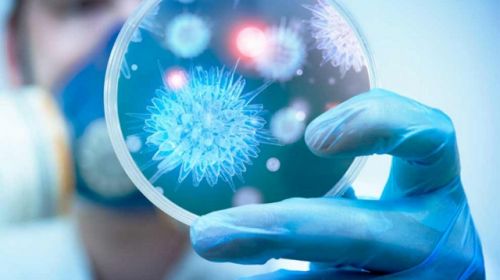

Новости
- 12.02.2018
Появилось видео с места столкновения автобуса и "BMW" в пригороде Херсона
Как сообщалось ранее, вчера возле поселка Текстильный произошла авария. На дороге в сторону Зеленовки столкнулись маршрутный...
- 12.02.2018
Для двух жителей Старой Збурьевки рыбка оказалась «золотой»
Двое жителей села Старая Збурьевка Голопристанского района, летом кормившиеся за счет своих огородов, в межсезонье решили...
- 12.02.2018
В Херсонской области расследуют гибель собаки
На Херсонщине расследуют гибель собаки. Животное стало жертвой пьяного мужчины. Дело рассматривает Новокаховский городской суд...
- 12.02.2018
"Чтобы Вас так оперировали, как Вы дороги делаете!", - врач о херсонском автодоре
Ужасное состояние херсонских дорог, огромные выбоины посреди проезжей части стали поводом недовольства автолюбителей. Водители...
- 12.02.2018
Вирусы атакуют детей и взрослых на Херсонщине
Первый «семейный» очаг заболевания корью появился в Каланчакском районе Херсонщины. Здесь этот недуг подхватили...
- 12.02.2018
В Херсоне горел частный дом
11 февраля в 17:53 на номер Службы спасения «101» поступила информация о пожаре по адресу: г.Херсон, ул.1-го Мая....
- 12.02.2018
Криминальная хроника за сутки
За прошедшие сутки в подразделения Национальной полиции в Херсонской области поступили 396 заявлений и сообщений, среди которых...
- 12.02.2018
Дело о двух индюках закончилось примирением
Житель с. Брускинское Великоалександровского района украл в канун Нового года, в обед 31 декабря 2017-го, двух индеек бронзовой...
- 12.02.2018
Херсонцы обратились к городским властям с просьбой снизить криминогенную обстановку
Херсонцы собрали подписи под обращением к органам местного самоуправления с просьбой принять меры по снижению криминогенной...
- 12.02.2018
Херсонцев предупреждают об опасном строительстве жилой многоэтажки
В Херсоне, на жилмассиве Корабел начато строительство многоэтажки. Однако, как заметили херсонцы, строители используют бывшие в...
- 12.02.2018
Херсонец поблагодарил ЖЭК за повышение цен и «отличную» уборку
Херсонец Иван Тыршу опубликовал в соцсети фото и прокомментировал: «Как хорошо, что в Херсоне есть ЖЕК «...
- 12.02.2018
Певец из Херсона Виктор Романченко презентовал новый клип
Певец из Херсона Виктор Романченко покорил всех своим голосом, исполняя известные рок-хиты. Учитель физкультуры стал известен...
- 12.02.2018
Коррупционная драма на Херсонщине: от фотографии до задержания на взятке
Увлекательная и в то же время драматическая история с коррупционным подтекстом развернулась в поселке городского типа Новая...
- 11.02.2018
В Херсоне автобус с пассажирами протаранил машину стоявшую на обочине
Около 19:30 автобус перевозчика Иксора, следовавший по маршруту "Херсон - Садово" ехал около ХДУ и на полной скорости...
- 11.02.2018
Херсонцы забросали ларек яйцами
На своем Youtube канале херсонец выложил видео о том, как его товарищи забросали местный ларек яйцами.
- 11.02.2018
В Херсоне автомобиль сбил пешехода
Вчера вечером в Херсоне произошло ДТП. Как сообщает в соцсетях Алексей Шумский, в микрорайоне Таврическом автомобиль сбил...